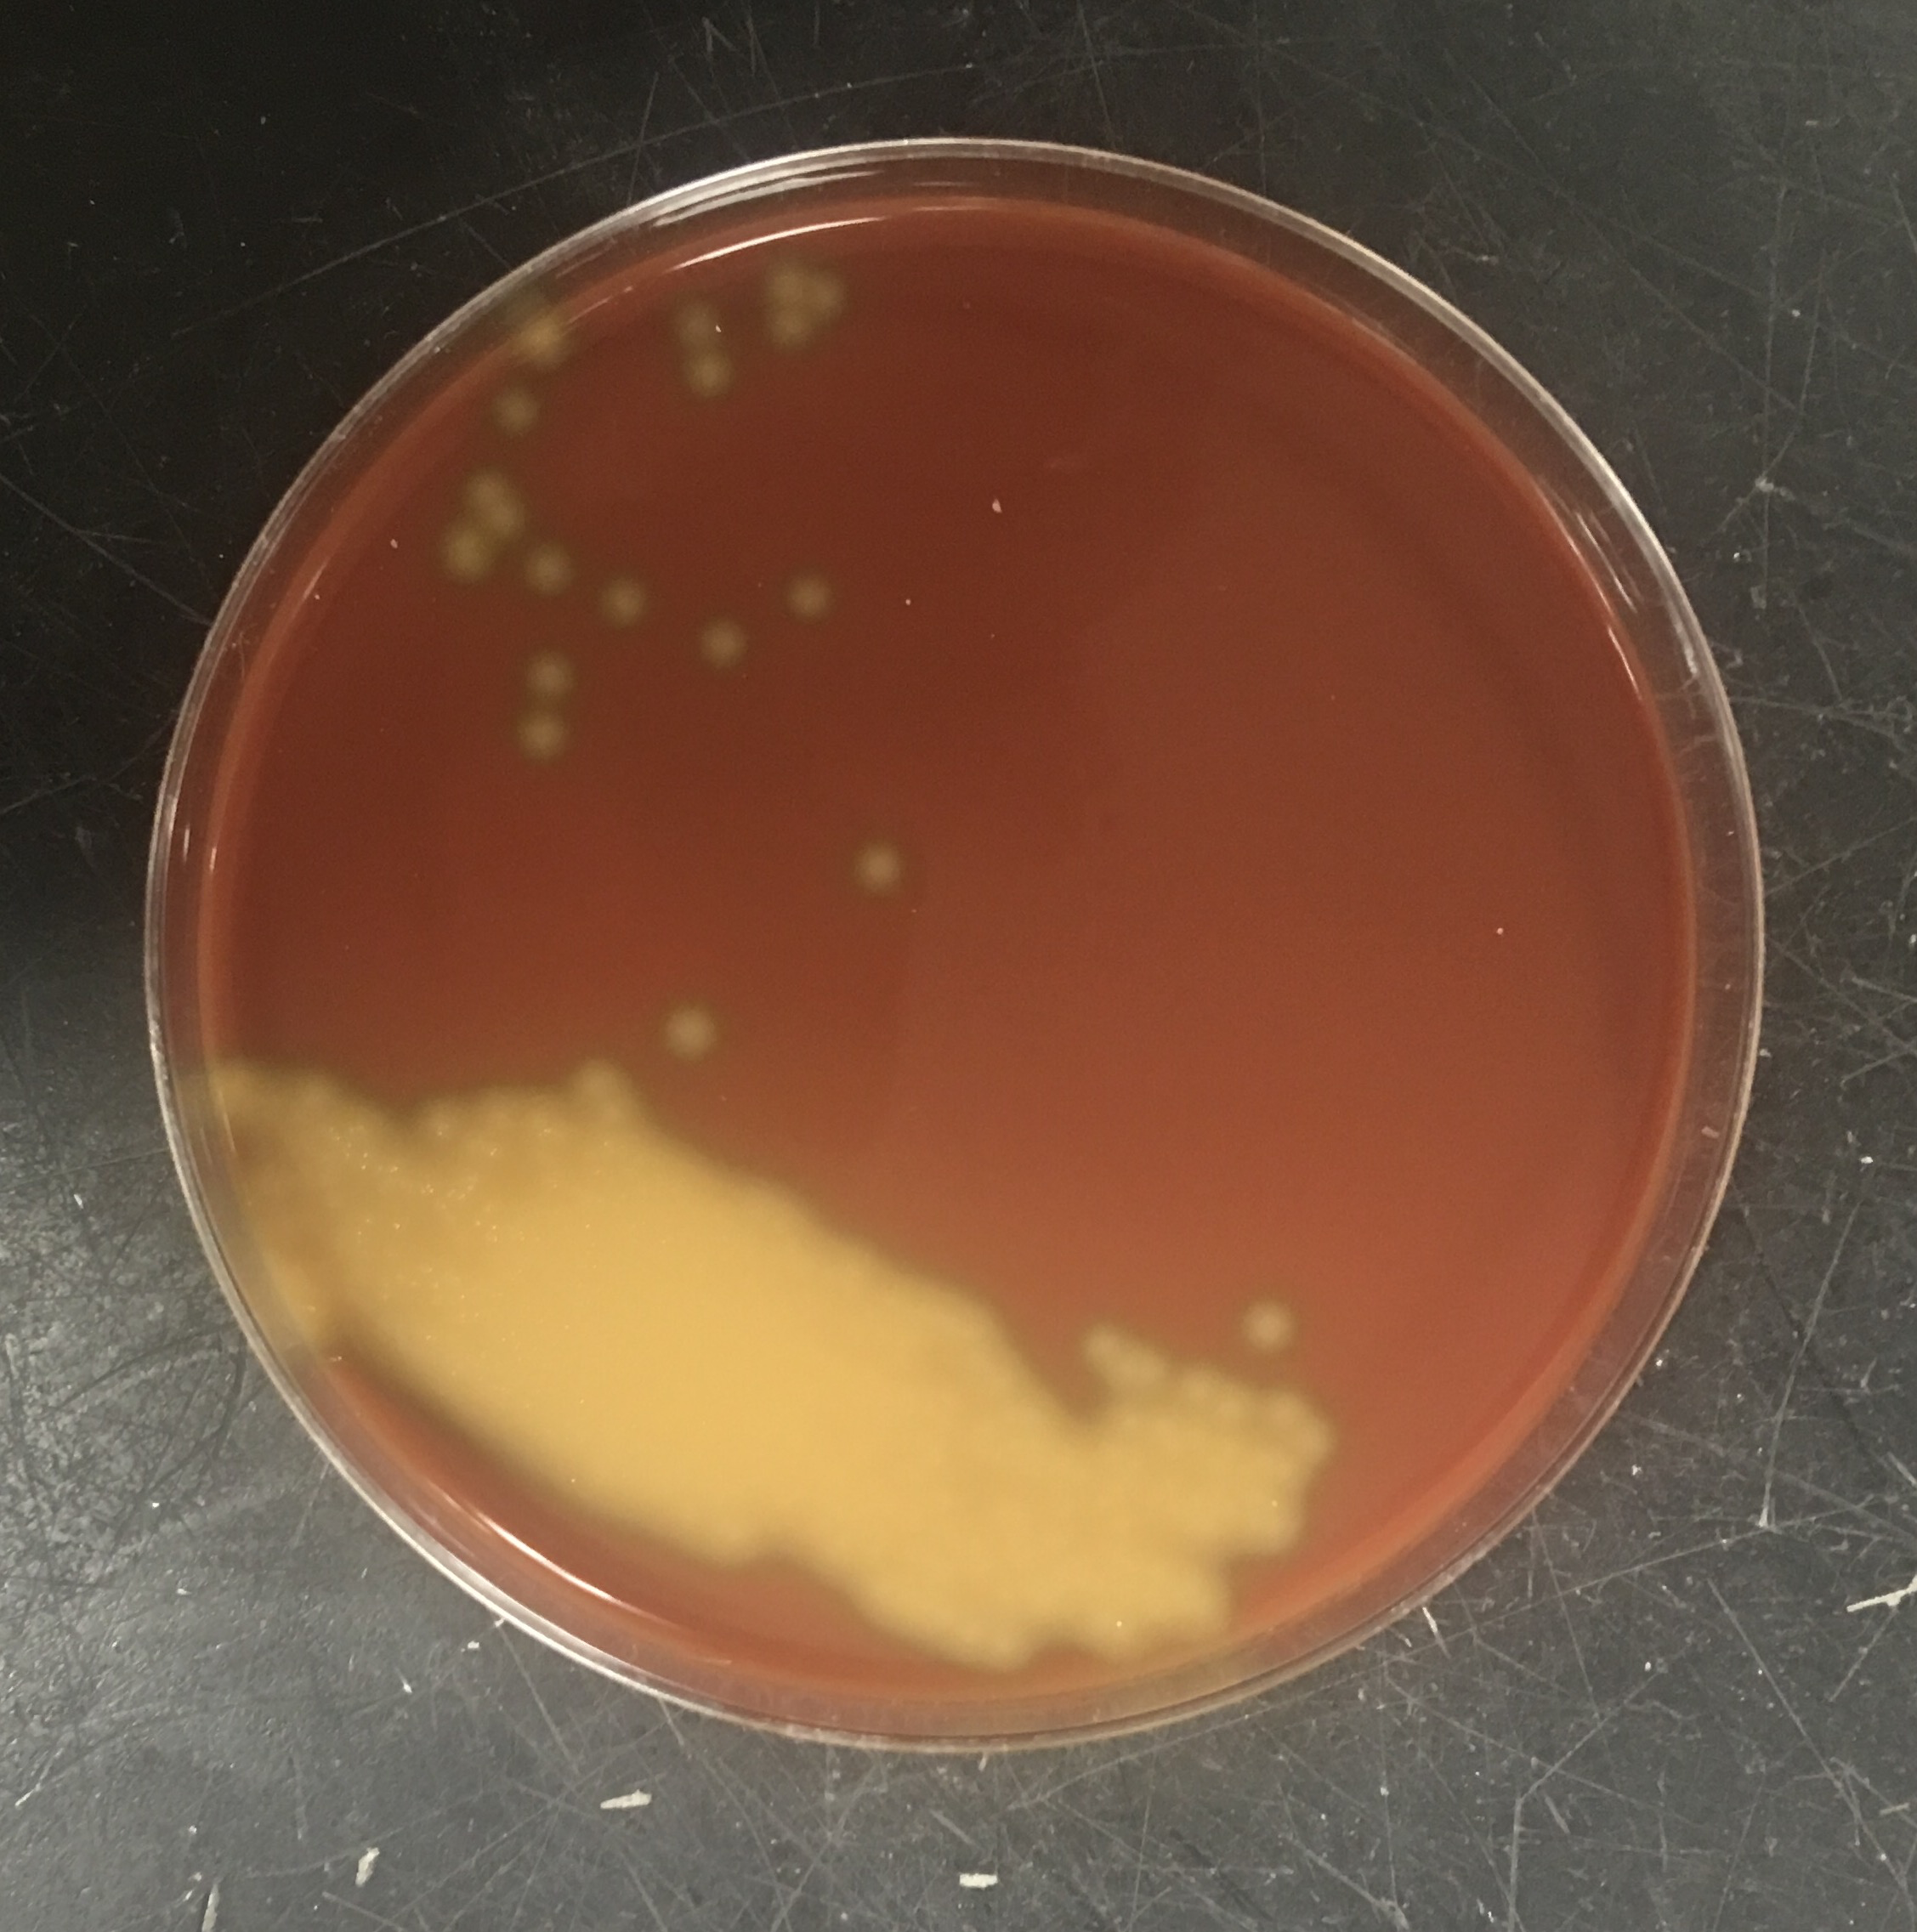

Питание стрептококка
Питание стрептококка 107 фотографий
Бизнес задачи магазина
Как оплатить тко красноярск по адресу
Курьер воронеж отзывы
Булочки вкусные без молоко
Печатное издание органов власти
Как растянуть блюстакс 5
Расписание 121 кемерово ясногорский
Зарядно пусковое 12 24
Банки дающие кредит на большую сумму
Болезни левого плеча